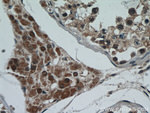
C13orf18 Antibody in Immunohistochemistry (Paraffin) (IHC (P))

Search
Proteintech
C13orf18 Polyclonal Antibody
{{$productOrderCtrl.translations['antibody.pdp.commerceCard.promotion.promotions']}}
{{$productOrderCtrl.translations['antibody.pdp.commerceCard.promotion.viewpromo']}}
{{$productOrderCtrl.translations['antibody.pdp.commerceCard.promotion.promocode']}}: {{promo.promoCode}} {{promo.promoTitle}} {{promo.promoDescription}}. {{$productOrderCtrl.translations['antibody.pdp.commerceCard.promotion.learnmore']}}
产品信息
21183-1-AP
种属反应
已发表种属
宿主/亚型
分类
类型
抗原
偶联物
形式
浓度
规格
纯化类型
保存液
内含物
保存条件
运输条件
产品详细信息
Immunogen sequence: MVSQSTVRQ DSPVEPWEGI SDHSGIIDGS PRLLNTDHPP CQLDIRLMRH KAVWINPQDV QQQPQDLQSQ VPAAGNSGTH FVTDAASPSG PSPSCLGDSL AETTLSEDTT DSVGSASPHG SSEKSSSFSL SSTEVHMVRP GYSHRVSLPT SPGILATSPY PETDSAFFEP SHLTSAADEG AVQVSRRTIS SNSFSPEVFV LPVDVEKENA HFYVADMIIS AMEKMKCNIL SQQQTESWSK EVSGLLGSDQ PDSEMTFDTN IKQESGSSTS SYSGYEGCAV LQVSPVTETR TYHDVKEICK CDVDEFV (1-306 aa encoded by BC032311)
靶标信息
This gene encodes a cysteine-rich protein that contains a putative zinc-RING and/or ribbon domain. The encoded protein is related to Run domain Beclin-1-interacting and cysteine-rich domain-containing protein, which plays a role in endocytic trafficking and autophagy. In cervical cancer cell lines, this gene is expressed at low levels and may function as a tumor suppressor. Promoter hypermethylation of this gene is observed in cervical cancer cell lines and tissue derived from human patients.
仅用于科研。不用于诊断过程。未经明确授权不得转售。
生物信息学
蛋白别名: KIAA0226 like; Pacer; Protein associated with UVRAG as autophagy enhancer; protein RUBCNL-like; Protein Rubicon-like; rubicon like autophagy regulator; RUN and cysteine rich domain containing beclin 1 interacting protein like; unnamed protein product
基因别名: C13orf18; KIAA0226L; PACER; RUBCNL
UniProt ID: (Human) Q9H714
Entrez Gene ID: (Human) 80183